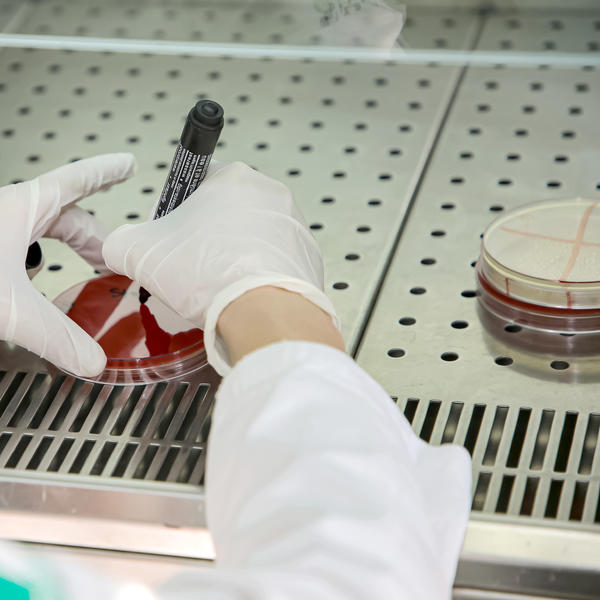
OGLASILO SE MINISTARSTVO SA NAJNOVIJIM VESTIMA O KORONAVIRUSU: Ovo su preneli svi mediji u Srbiji

Korona virus - Strana 1306
Najnovije vesti »
- 23:56hNema "sedmice" ali je četvoro igrača osvojilo "šesticu": Evo koja Loto kombinacija je večeras izvučena!
- 23:44hVladeta Jerotić: Roditelji se kunu da svoju decu vole jednako, ali tako nešto ne postoji
- 23:30hStefan otkrio za koga će navijati na Svetskom prvenstvu: Ronaldo je zaslužio da bude najbolji ikada!
- 23:15h"SVEKRVA JE DOŠLA KOD NAS NA VIKEND PA URADILA OVU BIZARNU STVAR" Ceo Balkan u neverici, ovo je potpuno suludo!
- 23:00h"USPEO JE DA PRODA HARIZMU" O Jakovu ne prestaje da se priče a progovorio je i on! "Svestan sam generacijskog jaza"
- 22:47hKremaste njoke spremne za pola sata: Hrskava slanina daje im poseban šmek, očas posla sve nestaje sa tanjira
- 22:41hNenad Kostić kroz suze o Edinu Avdiću - "legende kao ti nikada ne umiru" (Video)
- 22:35hToplotna kupola se zaglavila nad Balkanom! Jun će biti paklen, temperatura i do 35 stepeni, a onda POTPUNI HAOS!